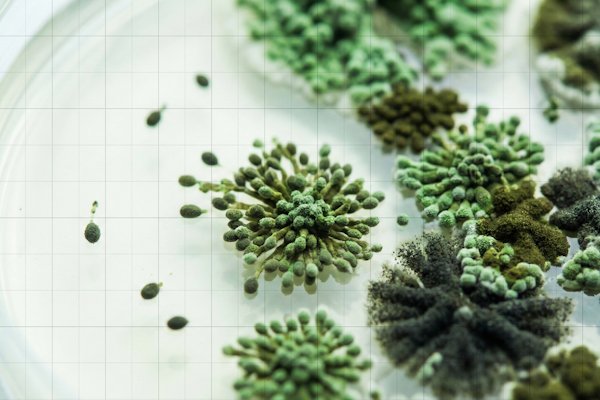
Mold & Indoor Air Quality Evaluations

Independent. Scientific. Nationwide Response.
When hurricanes, severe storms, floods, or catastrophic events strike, the damage to buildings and indoor environments can be extensive. Accurate assessment in the early stages of recovery is essential to protect occupants, document conditions, prevent unnecessary remediation, control project and claim costs, support proper restoration planning, and ensure safe re-occupancy of homes and buildings.
AirMD provides independent, science-based environmental evaluations to support insurance carriers, property managers, restoration contractors, government agencies, healthcare facilities, schools, hotels, construction teams, and real estate professionals during catastrophe response.
We do not perform remediation, our assessments are unbiased, defensible, and designed to guide responsible recovery.
How AirMD Assists After Hurricanes & Severe Weather Events
Our Core Services for Catastrophe Response
Moisture & Water Damage Assessment
Comprehensive moisture mapping, IR thermography, and causation analysis for post-storm water intrusion.
Mold & IAQ Testing
Rapid mold assessments, air quality testing, and clearance verification after remediation.
Asbestos & Lead Testing
Pre-remediation hazard assessments and compliance documentation for damaged buildings.
Smoke & Fire Damage Analysis
Soot, particulate, and chemical contamination testing after wildfires and fire events.
Water Quality Testing
Bacterial and chemical analysis for compromised potable water systems after catastrophic events.
Building Diagnostics
Envelope assessments, leak tracing, and thermal imaging to identify structural impact and moisture pathways.
Why Choose AirMD After a Catastrophe?
No remediation services = no incentives to over-scope.
Trusted by insurers, government agencies, and major organizations nationwide.
We scale teams to meet high-volume demand.
Designed for fast decision-making across multiple stakeholders.
Local presence backed by a national team.
Schools, hospitals, hotels, insurance, restoration, real estate, government, and more.
Partner With AirMD for Catastrophe Environmental Support
After hurricanes, storms, wildfires, floods, or severe weather, you need clarity, not assumptions. AirMD provides accurate, unbiased environmental data to guide safe, efficient, and cost-controlled recovery.
Protect your people. Protect your property. Protect your operations. Let AirMD help restore confidence after catastrophe.
Contact AirMD today to discuss how our catastrophe environmental testing services support your recovery efforts.